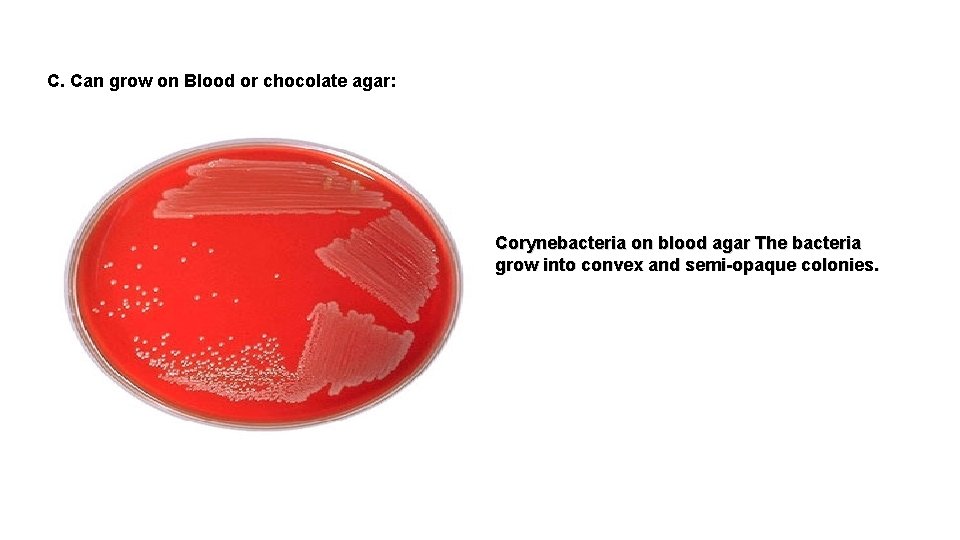
C. Can grow on Blood or chocolate agar: Corynebacteria on blood agar The bacteria

Practical No 13 Corynebacterium Mycobacterium Bacterial shape Cocci

Practical No. 13 Corynebacterium & Mycobacterium

Bacterial shape Cocci Bacilli Gram +ve Gram -ve Enterobacteriaceae Gram –ve Neisseria spp. Gram +ve Staphylococcus Streptococcus Spore forming: 1. Bacillus spp. (aerobic) 2. Clostridium spp. (anaerobic) Non - spore forming: 1. Corynebacteria spp. 2. Listeria spp.

Corynebacteria Pathogenic spp. C. diphtheriae Non– pathogenic spp. Diphtheriod (Normal URT) C. ulcerans & C. urealyticum

DISEASES LOCAL INFECTIONS: Respiratory diphtheria (production of exotoxin) Cutaneous diphtheria SYSTEMIC Necrosis of organs, Nerve damage.

Pathogenesis EXOTOXIN Bacteria never invades the blood

Diphtheria

C. diphtheriae Also called Kleb’s Loeffler Bacilli (KLB). Aerobic, non-spore, non – motile, Gram +ve bacilli. lose Gram’s stain easily.

Corynebacterium is a genus of Gram-positive rodshaped bacteria. They are widely distributed in nature. They are catalase positive, non-sporeforming, non-motile, rod-shaped bacteria that are straight or slightly curved. Metachromatic granules are usually present representing stored phosphate regions. Their size ranges from 2 – 6 µ in length and 0. 5 µ in diameter. The bacteria group together in a characteristic way, which has been described as the form of V or Y shape, or what is called "Chinese letters arrangement".

Special stains: Albert stain DARK granules, GREEN bacilli Neisser stain redish- purple granules, colorless bacilli.


The most notable human infection is diphtheria, caused by Corynebacterium diphtheriae. It is also known as the Klebs-Löffler bacillus. The bacteria which are only lysogenic for phage β are capable of producing a powerful cytotoxin. Production of this toxin leads to the formation of pseudomembranes which are composed of dead epithelial cells, dead and live white blood cells, red blood cells, and fibrin that form around the tonsils and back of the throat, which may lead to suffocation of the infected child.

Q: What are diagnostics features for Genus Corynebacteria?

Diagnostics criteria: 1 - Metachromatic granules (volutin). 2 - Club – shaped (swallow at one end ) 3 - Arrange in parallel or in acute angle, so called Chinese letters according to its appearance.

Laboratory diagnostic tests: Specimen Smear from a throat swab from a diphtheria case; 1. Gram stain; is performed to show gram-positive, highly pleomorphic organisms with no particular arrangement (classically resembling Chinese letters). Special stain like Alberts's stain is used to demonstrate the metachromatic granules (or polyphosphate, or Babes-Ernst granules). Fixed smear is prepared, Albert's stain is added for 3 -5 minutes, washed with tap water, lugol's iodine is applied for 1 minute, washed then dried and finally examined under the microscope. . The cytoplasm appears light green and the granules blue/black.

2. Culture: culturing the organism on an enrichment medium 1) Löffler's serum: is used primarily for the cultivation of corynebacteria. This is a firm coagulated serum medium containing nutrient broth, prepared as slants. It is a selective medium, does not enrich other oraganisms of the throat. K. L. B. appears small, circular, grey, opaque disks with regular borders. 2) tellurite agar (blood agar + potassium tellurite): It is a selective medium which allows all Corynebacteria (including C. diphtheriae) to reduce tellurite to metallic tellurium producing brown colonies and, only in the case of C. diphtheriae, a black halo appears around the colonies allowing for easy differentiation of the organism.

3) Tinsdale medium: It contains cystine–tellurite, this medium is light yellow , colonies of C. diphtheriae appear Small, brownish-black colonies surrounded by a brown halo in the agar. 4) Blood agar: assures the recovery of corynebacteria as well as any other pathogenic bacterial species that might be present, differentiating those that may be hemolytic.

Laboratory Diagnosis 1. Specimens : Throat swab. Skin swab. 2. Staining: Gram’s stain G + ve bacilli, Chinese letter. Albert's stain Metachromatic granules (dark), bacilli (green).

3. Culture: a. Loeffler’s agar. (Enriched media only) (12 -18 hr): contains serum or egg b. K+ tellurite blood agar (selective & enrichment media). 48 hr Black colonies Colonies appear gray-black due to tellurite reduction telluride
C. Can grow on Blood or chocolate agar: Corynebacteria on blood agar The bacteria grow into convex and semi-opaque colonies.

In vivo and in vitro tests: Elek's test for toxigenicity: It is an in vitro test performed only in reference to public health laboratories in order to know if the organism is able to produce the diphtheria toxin or not. Filter paper strep containing antitoxin is placed on agar plate. The tested culture is streaked across the plate. after 48 hours the antitoxin precipitates the toxin, resulting in the formation of bands between the filter paper and the bacterial growth.


4. Virulence test (Toxin production test): a. Guinea pigs lethality b. Gel-diffusion test (ELICK test): Line of precipitation

In vivo Schick's test; intradermal injection of 0. 1 ml of purified toxin. If a person does not have enough antibodies to neutralize that toxin, the skin around the injected area will become red and swollen, indicating a positive result. This swelling disappears after a few days. If the person has immunity, then little or no swelling and redness will occur, indicating a negative result.

Mycobacterium

Genus Mycobacterium Typical Mycobacterium (pathogenic) ØIn Healthy ØMan-Man ØEndemic in Iraq A typical Mycobacterium (non-pathogenic) ØIn AIDS and similar ØNo Man-Man

M. TUBERCULOSIS DIAGNOSTIC FEATURES: v. Obligatory aerobic. v. Non toxogenic. v. Intracellular M. O. v. Thin cylindrical long bacilli. v. Unique cell wall contains high lipid contents (60%).

Unique Cell Wall Mycolic acid, giving Waxy feature Resist decolorization by high acid concentration so the name "ACID FAST BACILLI = AFB" is given. Does not stain by Gram’s Stain

Mycobacterium The genus includes pathogens known to cause serious diseases in mammals, including tuberculosis and leprosy Mycobacteria are aerobic and nonmotile bacteria they are characteristically acidalcohol fast. Mycobacteria do not contain endospores or capsules. They are not classified as either Gram-positive or Gram-negative they are acid fast bacilli referring to their resistance to decolorization by acids during staining procedures.


Mycobacterium tuberculosis cell wall

Laboratory diagnostic tests; Specimen; sputum, CSF, joint fluids, urine gastric washings, biopsy material. Direct smear; Ziehl-Neelsen staining for examining the AFB (acid fast bacilli). In order to detect Mycobacterium tuberculosis in a sputum sample. One acid s regarded as "positive" of an MTB infection.

. 1 - Procedure; Strong carbol fuchsin is added to a fixed smear of sputum. Flood the slide with stain, heat until steaming. 2 - Decolorize with 20% H 2 SO 4. 3 - Wash with tap water. 4 - Add methylene blue for 1 minute (counter stain). 5 - Dry and examine under microscope. Acid-fast bacilli appear pink in a contrasting blue background.

DIAGNOSIS: Suspected Patient X-ray + Tuberculin Skin Test Take sputum Lab. Dx. very imp.

LABORATORY DIAGNOSIS: Specimens processing Prepare fixed smear on slide AFB stains SELECTIVE media

AFB stains FLOUROCHROME STAIN GREEN APPLE BACILLI BLACK BACKGROUND ZIEHL NEELSEN (Z N STAIN) LIGHT RED BACILLI WITH BLUE BACKGROUND

ZN stain


Another method is the Kinyoun method. The procedure for Kinyoun staining is similar to the Ziehl-Neelsen stain, but does not involve heating the slides being stained. The Kinyoun staining method uses carbol fuchsin as a primary stain, followed by decolorization with an acid-alcohol solution and methylene blue as a counterstain. Kinyoun carbol fuschsin has a greater concentration of phenol and basic fuchsin and does not require heating in order to stain properly. When viewed under a microscope; a Kinyoun stained slide will show acid-fast organisms as red and nonacid-fast organisms as blue.

Culture; Lowenstein-Jensen medium which is an egg based medium prepared as slants contain eggs, potato, serum, glycerol, malachite green and antibiotics. Colonies appear dry, rough, wrinkled; these bacteria are very slow growers it takes 4 -6 weeks until visible growth appears.

SELECTIVE MEDIA SOLID MEDIA LIQUID MEDIA Lowenstein – Jensen O 2 , 5% CO 2 , 37 C◦ ≥ eight wks TOUGH, ROUGH, BUFFY colonies BACTEC system 6 WKS

TOUGH, ROUGH, BUFFY colonies

BACTEC Mycobacteria diagnostic system

Tuberculin skin test



THANK YOU .
- Slides: 46